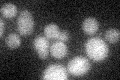
YOR239W
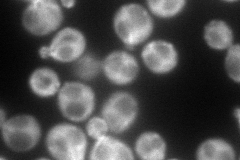
YOR239W
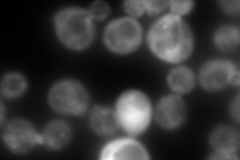
YOR239W
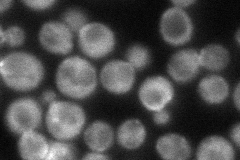
YOR239W
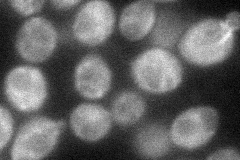
YOR239W
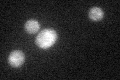
YOR239W

View description
Nonessential protein that binds actin filaments and localizes to actin patches and cables, has similarity to S-adenosylmethionine (AdoMet)-dependent methyltransferases
Localization:
Intensity:
Fold change:
Significance:
-
C’ GFP library in SD
below threshold16.79 -
N' NOP1pr-GFP in SD
cytosol,punctate,bud159.022 -
N' TEF2pr-mCherry in SD
cytosol,punctate,budN/A -
N' NATIVEpr-GFP in SD
punctate,bud neck78.5807 -
N' TEF2pr-VC and Cyto-VN in SD
cytosol58.1679 -
C’ GFP library in SD+DTT
cytosol16.831No -
C’ GFP library in SD+H2O2

cytosol19.431.15No -
C’ GFP library in Starvation Media

cytosol15.180.9No -
C’ GFP library on the background of Pup2-DaMP

below threshold -
C’ GFP library on the background of CCT mutant

below threshold17.79831.05935No
